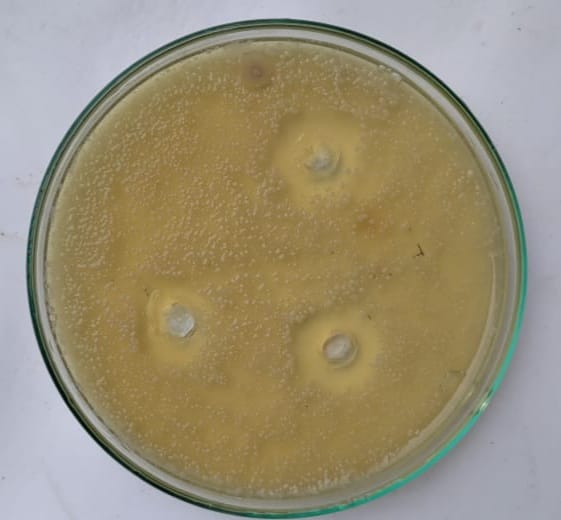

Sri Venkateshwara College of Pharmacy, Osmania University, Telangana
*Corresponding author: Ivaturi Bala Tripura Sundari; *Email: ibaluts@gmail.com
Received: 21 Aug 2023, Revised and Accepted: 06 Oct 2023
ABSTRACT
Objective: The present research has been undertaken with the aim to develop a topical nail gel formulation of Efinaconazole. Efinaconazole is considered highly desirable to treat common nail disorders such as Onychomycosis due to localized effects and improved adherence. Efinaconazole topical gel preparations are not yet available in the market thus, this formulation is made for better patient compliance. Efinaconazole nail gel is formulated with unique ingredients added to an alcohol-based formulation to provide low surface tension and good wetting properties.
Methods: The nail gels were formulated by using different gelling agents. Various formulations [F1-F10] were developed using a suitable polymer [Carbopol-934, Xanthan gum, CMC]. The formulations were evaluated for pH, viscosity, spreadability, % Drug content, extrudability, stability testing, in vitro drug diffusion studies, and in vitro antifungal activity.
Results: The results showed that Efinaconazole nail gel had good antifungal activity. Viscosity studies and pH studies revealed that formulation F2 was better when compared to other formulations. Results indicate that the 0.75% concentration of carbopol-934 is the ideal among other formulations.
Conclusion: It was concluded that formulation F2, containing a 0.75% concentration of Carbopol-934 was the best formulation of all.
Keywords: Efinaconazole, Carbopol-934, Xanthan gum, CMC
© 2023 The Authors. Published by Innovare Academic Sciences Pvt Ltd. This is an open access article under the CC BY license (https://creativecommons.org/licenses/by/4.0/)
DOI: https://dx.doi.org/10.22159/ijcpr.2023v15i6.3092. Journal homepage: https://innovareacademics.in/journals/index.php/ijcpr
Onychomycosis is a fungal infection of the nail unit caused by dermatophytes, yeasts, and non-dermatophyte molds. It is a common disease with a prevalence of 10%-12% in the US [1, 2]. The treatment objective is to eradicate the fungus and produce a normal nail. There are four approved classes of antifungal drugs for the treatment of Onychomycosis, allylamine, azoles, morpholines, and hydroxypyridinones [3].
Efinaconazole is the First azole FDA-approved in the USA to be used topically in the treatment of Onychomycosis [4].
Dermatophytes are the causative organism of toenail or fingernail fungal infection, which is a superficial fungus infection. A fungal microorganism infects the nail bed, causing the illness. Onychomycosis and Tinea unguium are two forms of a fungal nail infection. Finger nails and toenails thicken, darken, disfigure, and split as a result of a fungal nail infection called as mycotic nails [5, 6].
Efinaconazole, a triazole, is used for the treatment of Onychomycosis and is effective against a broad spectrum of fungal species. There may be extended therapeutic use of this drug beyond Onychomycosis in the future [7, 8].
Materials
Efinaconazole, Carbopol-934, Xanthan gum, Carboxy methyl cellulose, Ethanol, methylparaben, Triethanolamine, water.
Method
Carbopol-934, Xanthan gum, or CMC as polymer, purified water, and methylparaben as a preservative were taken in a beaker and allowed to stir on a magnetic stirrer. To the above mixture, required amount of organic phase [drug and ethanol mixture] was added. Triethanolamine as a pH adjuster was added dropwise with continuous stirring until a homogeneous nail gel was formed.
Table 1: Optimized formulation of efinaconazole nail gel
| Ingredients | F1 | F2 | F3 | F4 | F5 | F6 | F7 | F8 | F9 | F10 |
| Efinaconazole | 0.1g | 0.1g | 0.1g | 0.1g | 0.1g | 0.1g | 0.1g | 0.1g | 0.1g | 0.1g |
| Carbopol-934 | 0.05g | 0.075g | 0.1g | 0.15g | - | - | - | - | - | - |
| Xanthan gum | - | - | - | - | 0.05g | 0.1g | 0.15g | - | - | - |
| CMC | - | - | - | - | -- | - | - | 0.1g | 0.15g | 0.2g |
| Ethanol | 4 ml | 4 ml | 4 ml | 4 ml | 4 ml | 4 ml | 4 ml | 4 ml | 4 ml | 4 ml |
| Methylparaben | 0.01g | 0.01g | 0.01g | 0.01g | 0.01g | 0.01g | 0.01g | 0.01g | 0.01g | 0.01g |
| Water | 10 ml | 10 ml | 10 ml | 10 ml | 10 ml | 10 ml | 10 ml | 10 ml | 10 ml | 10 ml |
| Triethanolamine | To Adjust pH |
Evaluation of efinaconazole nail gels [11-15]
The formulated nail gel was evaluated for pharmaceutical properties like homogeneity, drug content, pH determination, spreadability and viscosity.
Homogeneity
The formulations were tested for their homogeneity by visual appearance after the nail gel was applied as a thin layer on the slide.
Drug content
The drug content of gels was determined by taking the weighed amount of gel into a 10 ml volumetric flask and the volume was made with methanol. The Samples were analyzed spectrophotometrically at 262 nm by using the below formula.

Determination of pH
The pH of all gel formulations was recorded using the pH meter. The gel formulations were suitably diluted for determining the pH.
Spreadability
The spreadability of gels was measured by the parallel plate method. 1g of the prepared gel was placed between two glass plates 10 x 10 cm. A weight of 100g was placed on the top. Then the diameter of the Samples between the plates was measured.
S = M. L/T
Where S= Spreadability, M= Weight tied to the upper slide
L=Length of a glass slide, T=Time taken to separate the slides
Viscosity
Viscosity determinations of the prepared gels were carried out by Brookfield viscometer using spindle no 64. It was measured at an angular velocity of 100rpm and at 37 °C temperature. The averages of two readings were used to calculate the viscosity and all the evaluations were conducted in triplicate.
Antifungal efficacy studies
The antifungal efficacy study against candida albicans was determined by agar diffusion method employing Cup Plate technique. Known concentrations of prepared Efinaconazole nail gel and placebo gels were poured into cups bored into a petri dish previously inoculated with test organism. After allowing diffusion of the gels for 2h, the agar plates were incubated at 37 °C for 48 h. The zone of inhibition of optimized nail gel was measured and compared with that of the zone of inhibition of placebo nail gel. The entire procedure was carried out in aseptic condition throughout the study and the study was conducted in triplicate.
In vitro study
Franz diffusion cell was used for the drug release studies. Presoaked dialysis membrane was clamped between the donor and the receptor chamber of the diffusion cell. Weighed amount of nail gel was placed onto the surface of the dialysis membrane. The receptor chamber was filled with freshly prepared PBS (pH-5.5) solution to solubilize the drug and the diffusion cell was placed on a magnetic stirrer. The sample (1.0 ml aliquots) was collected at suitable time intervals. Samples were analyzed for drug content by UV visible spectrophotometer after appropriate dilutions. Cumulative corrections were made to obtain the total amount of drug release at each time interval. The cumulative amount of drug released across the dialysis membrane was determined as a function of time.
Stability studies
The optimized nail gel was immediately evaluated for its homogeneity, pH, organoleptic and rheological properties. Then the gel was stored at three different temperatures, i.e., low temperature (4±2 °C), room temperature (27±2 °C), and hot temperature (40±2 °C), for 12 w. The organoleptic properties and pH of the gels were checked for every two weeks.
Table 2: Drug content of efinaconazole nail gel formulations
| Formulation code | Drug content (%) |
| F1 | 92.86±0.12 |
| F2 | 97.38±0.18 |
| F3 | 95.21±0.21 |
| F4 | 95.11±0.81 |
| F5 | 94.42±0.62 |
| F6 | 96.80±0.41 |
| F7 | 97.56±0.86 |
| F8 | 94.85±0.62 |
| F9 | 98.31±6.12 |
| F10 | 97.45±4.11 |
Drug content analysis was done for all the ten formulations and the values were expressed as mean±SD. The drug content of all the formulations was found to be uniform.
Table 3: Data showing physicochemical attributes of Efinaconazole Nail gel formulations
| Formulation code | Viscosity (cps) | PH | Spreadability (cm) |
| F1 | 1012±10 | 7.00±0.2 | 2.5±0.36 |
| F2 | 1023±10 | 6.45±0.1 | 2.1±0.44 |
| F3 | 1065±20 | 6.26±0.2 | 2.0±0.56 |
| F4 | 1202±10 | 5.83±0.3 | 1.5±0.24 |
| F5 | 1002±20 | 7.90±0.2 | 3.0±0.33 |
| F6 | 1212±10 | 7.81±0.1 | 2.8±0.43 |
| F7 | 1311±10 | 7.50±0.4 | 2.6±0.55 |
| F8 | 1015±10 | 7.83±0.2 | 3.4±0.36 |
| F9 | 1232±20 | 7.70±0.1 | 3.2±0.24 |
| F10 | 1246±20 | 7.60±0.5 | 3.0±0.44 |
Viscosity, pH and spreadability were performed for all the ten formulations and it was observed that the spreadability decreased with an increase in polymer concentration. This is because the higher the polymer concentration, the thicker and more viscous the gel will be. A thicker and more viscous gel will be more difficult to spread. Viscosity has been seen to be increased as polymer concentration increases. This is because the polymer molecules become more entangled with each other as the concentration increases. This entanglement creates more friction between molecules, which makes it more difficult for them to flow. The pH of formulations was found to be in the range of 5.8 to 7.8.
Table 4: In vitro drug release study
| Time (H) | F1 | F2 | F3 | F4 | F5 | F6 | F7 | F8 | F9 | F10 |
| 0 | 0 | 0 | 0 | 0 | 0 | 0 | 0 | 0 | 0 | 0 |
| 1 | 14.12±0.34 | 18.43±0.52 | 9.42±0.33 | 7.02±0.22 | 10.62±0.21 | 7.11±0.26 | 6.44±0.22 | 7.62±0.25 | 7.82±0.11 | 6.31±0.21 |
| 2 | 31.54±0.22 | 32.64±0.32 | 28.42±0.26 | 20.12±0.23 | 29.11±0.42 | 22.31±0.22 | 19.34±0.36 | 26.34±0.32 | 25.33±0.43 | 18.21±0.23 |
| 3 | 48.62±0.55 | 51.36±0.63 | 48.45±0.24 | 36.33±0.21 | 46.43±0.18 | 38.26±0.19 | 32.11±0.37 | 39.36±0.24 | 40.22±0.21 | 31.32±0.25 |
| 4 | 69.33±0.31 | 72.44±0.38 | 65.58±0.33 | 48.41±0.12 | 68.22±0.26 | 50.28±0.21 | 47.42±0.22 | 53.23±0.21 | 54.22±0.32 | 49.43±0.14 |
| 5 | 82.40±0.32 | 85.53±0.46 | 79.24±0.32 | 65.22±0.24 | 80.20±0.44 | 65.27±0.42 | 60.35±0.21 | 68.37±0.22 | 69.24±0.16 | 61.32±0.24 |
| 6 | 96.77±0.41 | 98.31±0.44 | 90.45±0.21 | 82.33±0.12 | 94.11±0.24 | 85.34±0.43 | 75.36±0.24 | 85.21±0.28 | 80.27±0.25 | 74.21±0.31 |

Fig. 1: In vitro drug release study
The drug release study was done for all the ten formulations using Franz’s diffusion cell. The study was conducted for 6 h with an optimal interval of sampling. Results were shown in table 4 and fig. 1. In vitro release is 74 to 98% at the end of 6th h. Among all the ten formulations, F2 formulation exhibited 98.31±0.44% of drug release at the end of the study.
The formulated gels were tested for antifungal activity. The results are shown in fig. 2, 3 and table 4
Table 4: Evaluation of antifungal activity by agar well diffusion method
| Samples | Zone of inhibition in mm | Fungal culture |
| Placebo | - | Candida albicans |
| Gel-(Carbopol-934) | 10.6 |

Fig. 2: Placebo nail gel formulation
Anti-fungal efficacy of the optimized nail gel formulation and placebo nail gel was performed by agar diffusion method and from the above table zone of inhibition of the placebo formulation was zero when compared to the optimised formulation F2 which showed 10.6 mm. However, a larger zone of inhibition indicates that the fungal isolate is more susceptible to antifungal agent.
Fig. 3: Antifungal activity of optimized formulation (F2) nail gel
Table 5: Stability studies of gel formulations
| Formulation code | Appearance | Spreadability (cm) | Viscosity (cps) | pH |
| F2 | Homogenous | 2.14±0.42 | 1014±10 | 6.5±0.1 |
Stability studies for the optimized F2 formulation was performed. It has homogenous appearance and 2.14 cm spreadability and 1014 viscosity cps and have a pH 6.5. All the properties are having ideal characteristics for good stability.
The purpose of the present investigation was to formulate and evaluate the efinaconazole nail gel for the treatment of onychomycosis. Various nail gel formulations (F1 to F10) were developed using a suitable polymer (Carbopol-934, Xanthan gum, CMC). Developed formulations of Efinaconazole were evaluated for the physiochemical parameters such as drug content, pH, viscosity, spreadability, extrudability, in vitro drug diffusion studies, and in vitro antifungal activity. Viscosity studies, PH studies, and in vitro drug diffusion studies of various formulations revealed that formulation F2 was ideal when compared to others. Stability studies of gel formulations carried out were satisfactory. Efinaconazole nail gel demonstrated antifungal efficiency against candida albicans. It can be concluded that the side effects of oral therapy of antifungal agents for onychomycosis can be avoided by using topical efinaconazole nail gel formulation, which serves as a better tool for ungual drug delivery.
Nil
All the authors have contributed equally.
Declared none
Ghannoum MA, Hajjeh RA, Scher R, Konnikov N, Gupta AK, Summerbell R. A large-scale North American study of fungal isolates from nails: the frequency of onychomycosis, fungal distribution, and antifungal susceptibility patterns. J Am Acad Dermatol. 2000;43(4):641-8. doi: 10.1067/mjd.2000.107754, PMID 11004620.
Scher RK, Rich P, Pariser D, Elewski Boni. The epidemiology, etiology, and pathophysiology of onychomycosis. Semin Cutan Med Surg. 2013;32(2) Suppl 1:S2-4. doi: 10.12788/j.sder.0014, PMID 24156160.
Welsh O, Vera Cabrera L, Welsh E. Onychomycosis. Clin Dermatol. 2010;28(2):151-9. doi: 10.1016/j.clindermatol.2009.12.006, PMID 20347657.
Lipner SR, Scher RK. Efinaconazole in the treatment of onychomycosis. Infect Drug Resist. 2015;8:163-72. doi: 10.2147/IDR.S69596, PMID 26082652.
Maji HS, Chatterjee R, Das D, Maji S. Fungal infection: an unrecognized threat. In: Bagchi D, Das A, Downs BW, editors. Viral, parasitic, bacterial, and fungal infections antimicrobial, Host Defense, and Therapeutic Strategies. Academic Press; 2023. p. 625-44.
Piraccini BM, Sisti A, Tosti A. Long-term follow-up of toenail onychomycosis caused by dermatophytes after successful treatment with systemic antifungal agents. J Am Acad Dermatol. 2010;62(3):411-4. doi: 10.1016/j.jaad.2009.04.062, PMID 20159308.
Scher RK, Baran R. Onychomycosis in clinical practice: factors contributing to recurrence. Br J Dermatol. 2003;149Suppl 65:5-9. doi: 10.1046/j.1365-2133.149.s65.5.x, PMID 14510969.
Park NH, Shin KH, Kang MK. Pharmacology and therapeutics for dentistry. 7th ed. Mosby; 2017. p. 488-503.
Patel T, Dhillon S. Efinaconazole: first global approval. Drugs. 2013;73(17):1977-83. doi: 10.1007/s40265-013-0152-x, PMID 24249649.
Patel B, Banwait H, Parmar K, Patel M. Formulation and evaluation of topical aceclofenac gel using different gelling agents. Japan Patel. Int J Drug Dev Res. 2011;3:156-64.
Mulay KV, Birajdar AS, Gaikwad PD. Formulation and evaluation of antimicrobial gel of tinidazole. Int J Sci Res. 2019;8:1744-6.
Niyaz Basha B, Prakasam K, Goli D. Formulation and evaluation of gel containing fluconazole-antifungal agent. Int J Drug Dev Res. 2011;3:109-28.
Parashar B, Kabra A, Chandel A. Formulation and evaluation of gel containing miconazole nitrate an antifungal agent. Int J Pharm Res Rev. 2013;3:18-28.
Botre PP, Maniyar MG. Formulation and evaluation of solid lipid nanoparticles of Bifonazole. Int J Sci Res Sci Tehnol. 2020;7:105-20.
Swetha M, Mohan B, Narsimha Rao R, Kumar JNS, Satyavathi PS. Formulation and evaluation of flubiprofen emulgel by using different concentrations Carbopol 974 M. Saudi J Pharm Sci. 2018;4:215-25.